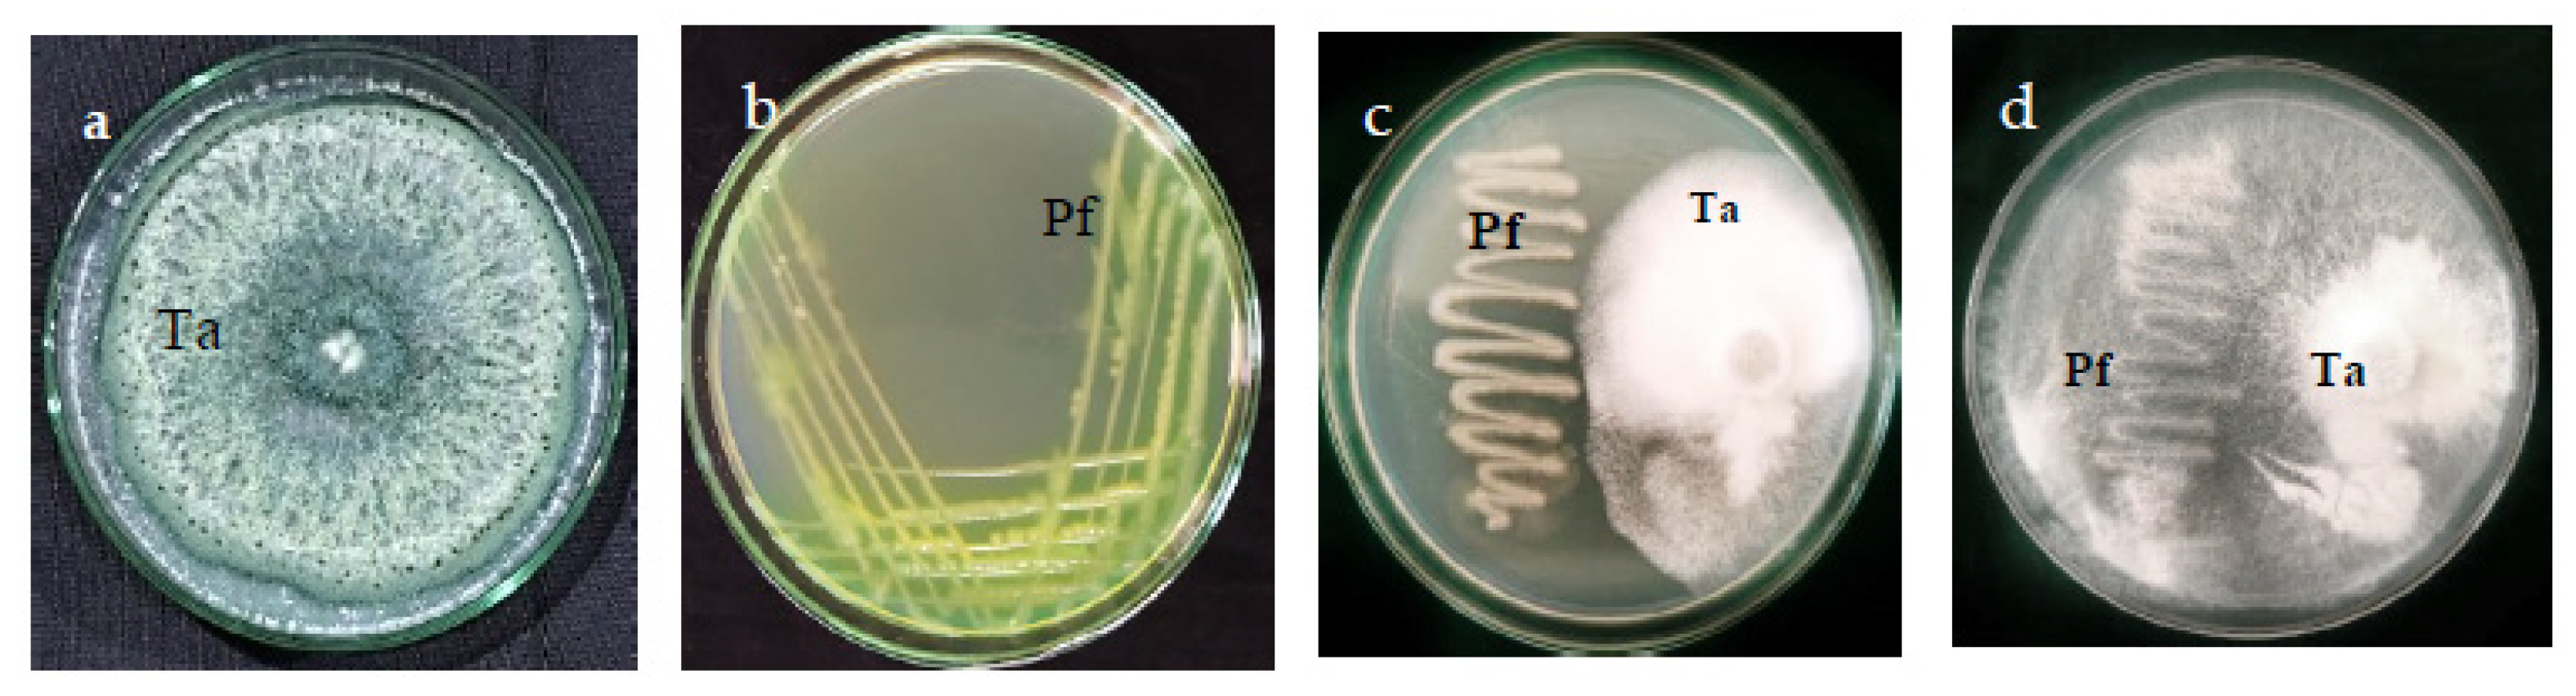
Microbiolres 16 00151 g002
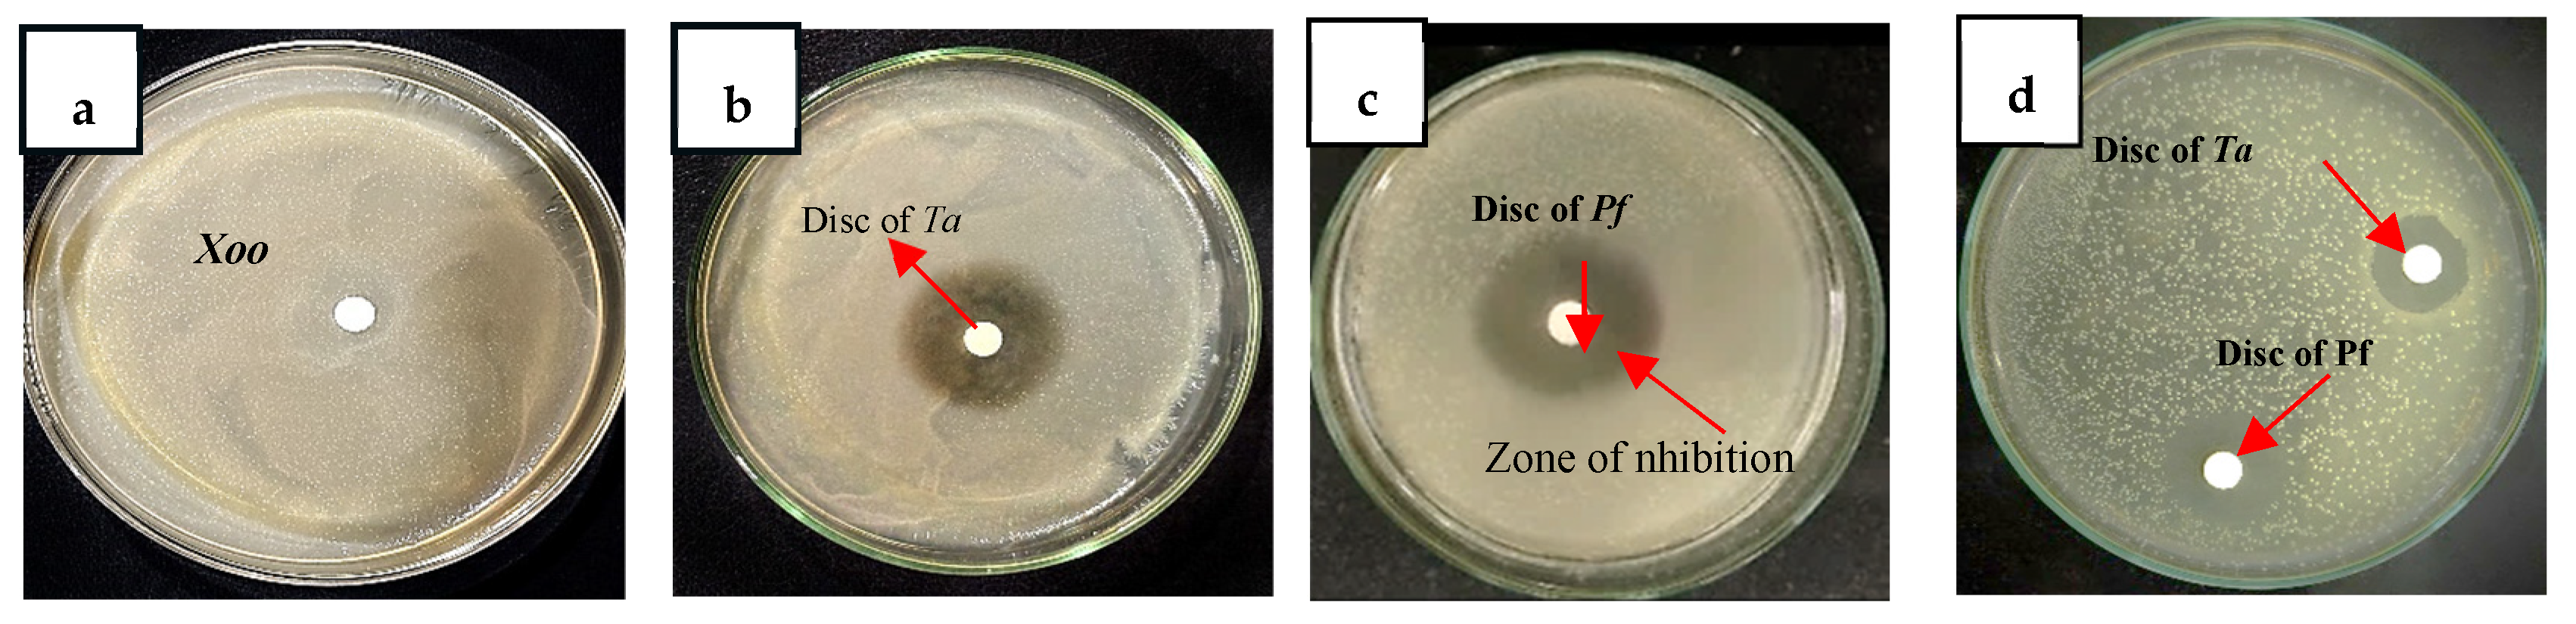
Microbiolres 16 00151 g003

Abstract
Plant-beneficial microbes are a perennial ally in an agroecosystems, providing multiple benefits to crop plants. The present study explored the potential of two microbial biocontrol agents (MBCAs), viz., Trichoderma asperellum and Pseudomonas fluorescens, against the bacterial blight pathogen of rice, Xanthomonas oryzae pv. oryzae. In vitro, MBCAs resulted in significant inhibition of X. oryzae pv. oryzae, as evidenced through the distortion of pathogen cell morphology and formation of a pathogen biofilm. Pot studies on the effect of MBCAs in rice showed increased germination, increased vigor index of seedlings, increased tiller numbers, a 10.29% reduction in percentage disease incidence (PDI), and low disease severity following individual inoculation. Activity of plant defense enzymes also increased with MBCA treatment (phenylalanine ammonia-lyase, 2.7-fold increase; peroxidase and polyphenol oxidase, 5-fold increase), establishing the priming effect of MBCAs on host defense. The quantitative polymerase chain reaction data revealed that pathogenesis-related genes (OsPR1a, OsPR1b, and OsPR10a) and X. oryzae pv. oryzae resistance genes (Xa1 and Xa26) were upregulated 4- to 14-fold in MBCA-treated rice plants over control plants. These results provide insights into the phenological, physiological, and molecular responses of rice crops treated with MBCAs in the presence of X. oryzae pv. oryzae and could be used to develop an effective field management strategy.
1. Introduction
Rice (Oryza sativa L.) is a crop of paramount importance, as it is a staple food for a substantial fraction (30–40%) of the global populace, with its cultivation ensuring food security. Rice production in India is a significant agricultural activity. India is the lead exporter and the second-largest producer of rice in the world, having recorded an increase in production from 53.60 million tons in 1980 to 120 million tons in FY 2020−21 [1,2]. The crop is mainly grown in areas that receive heavy annual rainfall, and the primary rice-growing regions include states such as West Bengal, Uttar Pradesh, Andhra Pradesh, Punjab, and Tamil Nadu [3]. Nonetheless, a formidable threat is posed by various pathogens that jeopardize the sustainable production of rice, with bacterial blight disease as a major concern. The major symptoms include “kresek” (wilting of seedlings) and blight of the leaves [1]. The disease first appears as water-soaked lesions with wavy signs on rice leaf margins at the tillering stage; these lesions further expand along the veins as elongated, necrotic, straw-colored areas in the later stages, and wilting also occurs. Collectively, these symptoms cause reduced photosynthesis and, ultimately, substantial reduction in yield [2]. India’s diverse agro-climatic zones create favorable conditions for the rapid spread of this disease [3], culminating in potential yield losses up to 50–80% [4] and thereby presenting a considerable challenge to rice cultivation on a global scale given the limited availability of field-resistant rice varieties [3]. Losses due to bacterial blight disease occur both in terms of yield quantity and quality, affecting the livelihoods of countless farmers who heavily depend on rice cultivation [5]. Traditionally, disease management heavily relies on chemical treatments including antibiotics; as a result, their residues accumulate in soil, water, and the food chain, leading to ecological and health risks to consumers and agricultural workers [5]. Antibiotics, once hailed as wonderful weapons against bacterial and fungal diseases of plants, are now facing a crisis of effectiveness in combating plant diseases due to development of antibiotic resistance in plant pathogens [6]. Therefore, alternative methods such as integrated management and microbe-based solutions have become favored for exploration in the field [5]. These alternatives emphasize sustainability, minimize health and environmental hazards, and promote the long-term viability of agriculture, ensuring food security for future generations. However, mitigating the impact of bacterial blight disease in India requires a more comprehensive approach, including the development and promotion of disease-resistant rice varieties and the adoption of bio-intensive integrated disease-management practices.
In response to these challenges, there is renewed emphasis on the exploration and development of sustainable and ecologically benign alternatives to mitigate the adverse impact of bacterial blight disease on rice production. The pursuit of effective and eco-friendly strategies has catalyzed an intensive exploration of microbial biocontrol agents (MBCAs) such as Trichoderma spp. and Pseudomonas spp. These bioagents have evoked significant interest due to their inherent potential to act as direct antagonists, as they produce an array of antimicrobial compounds known to have inhibitory effects on a wide range of bacterial and fungal phytopathogens. They also have the potential to act as biostimulants that result in enhanced seed germination, seedling vigor, and crop vigor [6]. Moreover, Trichoderma and Pseudomonas have extensively demonstrated their capacity to prime the host’s defense mechanisms against pathogen attack via the activation of signaling molecules and defense enzymes such as polyphenol oxidase (PPO), phenylalanine ammonia-lyase (PAL), and peroxidase (P0) [7]. These antioxidant enzymes assist crop plants in mitigating the effects of the reactive oxygen species that accumulate in plant cells during pathogenic invasion. PAL, the key enzyme in the phenylpropanoid pathway, is responsible for synthesis of phenols and lignin, and PO and PPO are involved in the production of phenolics, thus contributing to the reinforcement of cell barriers [8].
While the current research literature has highlighted the biocontrol potential of Trichoderma and Pseudomonas spp. across diverse plant-pathogen systems, the role of these microbes in protecting against X. oryzae pv. oryzae (the cause of bacterial blight disease) and their effects in co-inoculation with respect to the diverse modes of action of fungal and bacterial bioagents in rice are still inadequately experimented. Further, a limited number of studies have been conducted to elucidate the effect of the crosstalk between co-inoculated microbes in terms of inducing the expression of pathogenesis-related genes (defense genes) and genes associated with resistance to bacterial blight; studies on the real-time expression patterns of these genes in rice have also been limited. Hence, the present study was carried out to add to our understanding with regard to the following: i. in vitro assessment of beneficial microbes for protection against X. oryzae pv. oryzae, the cause of bacterial blight disease in rice, as observed in ultrastructural changes; ii. effect of beneficial microbes on seed germination and assessment for growth-promoting attributes and effects on susceptibility to bacterial blight disease; and iii. insights into the mechanisms underlying the elicitation of host defense enzymes and the real-time expression of PR genes and resistance genes in response to bioagents. These objectives could be helpful in formulating strategies for the sustainable management of bacterial blight disease in rice.
2. Materials and Methods
2.1. Microbial Cultures and Rice Cultivar
The well-characterized rice pathogen X. oryzae pv. oryzae (the cause of bacterial blight disease), GenBank accession number PQ285353 (Supplementary Figure S1), was obtained from the Pathogen Culture Bank of Assam Agricultural University—Assam Rice Research Institute (AAU-ARRI), Jorhat, Assam, India. The bacterial blight-susceptible rice variety Ranjit [9] was also obtained from the institute. The study employed two strains of MBCAs: Trichoderma asperellum (GenBank accession number ON364136; NBAIM accession number NAIMCC-F-04325) and Pseudomonas fluorescens (GenBank accession number KT258013; NBAIM accession number NAIMCC-B-03227) from the author’s Microbial Culture Bank of Biocontrol Laboratory, AAU, Jorhat, Assam, India. For the pot experiment, standardized bioformulations of T. asperellum (AAU-Bioshakti), and P. fluorescens (Biomonas) developed and produced at Biocontrol Laboratory, Department of Plant Pathology, AAU, Jorhat, Assam (India) were used.
2.2. Pathogenicity Assay of X. oryzae pv. oryzae Isolate
The pathogenicity of X. oryzae pv. oryzae was studied using a standard method of clip inoculation with the bacterial blight-susceptible rice variety Ranjit [10,11]. The X. oryzae pv. oryzae inoculum was prepared following a standard protocol [12]. Briefly, a purified X. oryzae pv. oryzae isolate maintained in nutrient agar (NA) (Hi-Media, Thane, Maharashtra, India)- slant was initially transferred to 100 mL nutrient broth (NB), then incubated with rotary agitation (150 rpm) at 28 °C for 24 h. The culture in NB was then centrifuged at 5000 rpm for 5 min, and pelleted X. oryzae pv. oryzae cells were harvested and the supernatant was discarded. The pellets were washed with sterile distilled water and resuspended. Bacterial cell density was determined using a spectrophotometer by measuring the optical density at 600 nm (OD600). The spectrophotometer (Model: MILTON ROYSPECTRONIC 21 D, Denver, CO, USA) was calibrated with a blank (sterile medium or buffer) to eliminate background interference. A standard curve was generated by measuring the OD600 of suspensions with known cell densities, establishing a linear relationship. The final cell density of 2 × 108 cells/mL was determined by comparing the sample’s OD600 to the standard curve, ensuring thorough mixing to avoid cell clumping.
At 45 days after transplantation, the pot-grown rice plants in sterilized soil were experimentally inoculated with the prepared X. oryzae pv. oryzae inoculum through the leaf-clipping method. The leaves were cut 3–4 cm from the top using sterile scissors dipped in bacterial suspension, and inoculation with distilled water was used as a control [11,12]. The pots were maintained in a greenhouse at 90% relative humidity (RH) and 29 °C temperature. The inoculated plants were observed continuously for the development of symptoms.
Re-isolation of the pathogen was done to confirm the identity of the pathogen as per Koch’s postulates. Briefly, leaf pieces from bacterial blight-infected leaves were excised from the advancing lesion on the leaf margin with sterilized scissors and surface-sterilized by immersion in 75% ethanol for 1 min under aseptic conditions, then rinsed three successive times with sterile distilled water. The surface-sterilized leaves were cut into bits, blot-dried, placed in the Petri plates containing NA medium, and incubated at 28 ± 2° C for 2 days. A single colony of X. oryzae pv. oryzae was isolated and grown in both NA and sucrose peptone agar (SPA) media [11].
2.3. In Vitro Compatibility Test of Bioagents
The compatibility of T. asperellum and P. fluorescens was tested using a dual-culture technique. The pure cultures were maintained on PDA and NA media (Hi-Media). Five-day-old disc plugs of T. asperellum (5 mm diameter) were aseptically transferred with a cork borer and cultured on one side of the solidified media; P. fluorescens was transferred and cultured by streaking on the other side of the same plate. The plates were incubated at 25 ± 2 °C, and growth of both organisms was observed at 24 h intervals until full growth was achieved. The experiment was repeated thrice [13].
2.4. In Vitro Bio-Efficacy Assay
The antagonistic activity of T. asperellum and P. fluorescens against X. oryzae pv. oryzae was assessed using a sterile disc inoculation assay. Pure cultures of T. asperellum and P. fluorescens were prepared in potato dextrose broth (PDB) and nutrient broth (NB) (Hi-Media), respectively, and incubated in a BOD incubator (Model: Scigenics, Orbitek BOD350L, Kuala Lumpur, Malaysia) at 28 ± 2 °C for 3 days. Concurrently, the bacterial pathogen X. oryzae pv. oryzae was also inoculated in NA and incubated for 24 h. Sterile discs were inoculated with T. asperellum and P. fluorescens for 24 h, while, for control plates, sterile discs were inoculated with distilled water (dH2O). The pure culture X. oryzae pv. oryzae was spread evenly on NA plates using the spread plate technique. The inoculated discs were carefully placed at the center of the agar plates. Each treatment was replicated six times, and the plates were incubated at 28 ± 2 °C for two days [11,14]. Finally, the inhibition zones, growth patterns, and bacterial cell aggregation were examined, and the antagonism was expressed as mean radial zone of inhibition [15].
2.5. Scanning Electron Microscopy (SEM) Analysis
The ultrastructural changes in the pathogen cells in response to MBCA treatments were observed using SEM. The samples were fixed by immersion in 2% glutaraldehyde for 30 min and then washed with ethanol gradients (30%, 50%, 70%, and 99%) for 15 min each, then dried in a vacuum chamber (JFC-1600 AUTO FINE COATER, JEOL, Petaling Jaya, Malaysia) for 3 h before being deposited on supports and spray-coated with colloidal gold particles [16]. Observations were made using a 30 kV SEM (Model: JEOL 6390 LV, Zhubei, Taiwan, China).
2.6. Pot Experiment Setup
A pot experiment was conducted under greenhouse conditions at the Department of Plant Pathology, AAU, Assam (India) from July to November for two consecutive years (2022–2024) to evaluate the bio-efficacy of T. asperellum and P. fluorescens against the selected pathogen in rice. The greenhouses were maintained at 28 ± 1 °C temperature and 80% RH. The soil was collected from the Experimental Farm, Jorhat, Assam (India) and sterilized in an autoclave (121 °C and 15 pounds per square inch) for 3 days, and pots (dimension: 30 cm× 25 cm ×25 cm) were washed with clean water, then with ethyl alcohol (70% for 2 min) before use. The following treatments were formulated:
- T1: Positive control (inoculation with Xoo at 108 CFU/mL on the 45th day after transplantation)
- T2: Seed treatment with T. asperellum formulation (1%) for 1 h + two foliar sprays (1%) at 45 and 60 days after transplantation (DAT)
- T3: Treatment of seeds with P. fluorescens formulation (1%) for 1 h + two foliar sprays (1%) at 45 and 60 DAT
- T4: Treatment of seeds with T. asperellum (1%) and P. fluorescens (1%) for 1 h + two foliar sprays carrying T. asperellum + P. fluorescens (1% each) at 45 and 60 DAT
- T5: Negative control (clip inoculated with sterilized water only)
Challenge inoculation of the pathogen was done at 45 DAT in T1, T2, T3, and T4 before application of bioagents. The experiment was designed with a completely randomized design (CRD) with six replicates.
2.6.1. Observations on Percentage Seed Germination and Seedling Vigor
The observations on seedling vigor index (SVI) were made using the formula SVI = RL + SL × GP, where RL, SL, and GP are root length, shoot length, and germination percentage, respectively [17]. The germination percentage was recorded 7 days after treatment.
2.6.2. Observations on Plant Growth Parameters and Disease Index
Plant growth parameters, viz., number of tillers and plant height, were recorded at 50 and 70 DAT. The bioagents were assessed in vivo for the suppression of bacterial blight under natural light and temperature conditions using replicates for each treatment and three plants per pot [9].
Lesion length was measured at 15 days post-inoculation. The growth attributes, specifically, tiller number and plant height, were recorded at 15-day intervals until 70 days had passed. Suppression of the disease was measured in terms of reduction in mean lesion length on treated leaves compared to the uninoculated control using the following formula: Diseased Leaf Area (% DLDA) = Total lesion length of the test sample/Total leaf length of the test sample × 100.
Mean disease severity scores were obtained (Supplementary Table S1) using the IRRI standard evaluation system for rice.
Disease severity (PDS) was calculated following the formula given by Wheeler in 1969 [18], as follows:
The Percent Disease Incidence (PDI) was also calculated using the following formula [19]:
2.6.3. Enzyme Assays
Activity of antioxidant defense enzyme, including peroxidase (PO), polyphenol oxidase (PPO), phenylalanine ammonia-lyase (PAL), and β-1,3-glucanase, was assessed in rice leaves.
Leaf samples were ground in a grinding machine to obtain a homogeneous powder, then subjected to enzyme extraction according to a standard protocol [20]. Leaves from each treatment group were collected from individual replicates, pooled together, and subsequently divided into three subsamples, each weighing 2 g. These subsamples were randomly selected and immediately frozen in liquid nitrogen for subsequent analysis. Powdered leaf tissues were suspended in cold 0.05 M phosphate buffer (pH 7.0) containing 0.5 g polyvinyl polypyrolidone (PVP) in a 1:5 ratio.
Assay of PAL
The spectrophotometric determination of PAL activity was carried out by monitoring the generation of trans-cinnamic acids from L-phenylalanine [21]. The reaction mixture in each tube comprised 100 μL of the enzyme extract, 1.15 mL of 0.1 M borate buffer (pH 8.8), and 1 mL of 10 mM L-phenylalanine. Subsequently, the mixture was incubated at 40 °C for 1 h in a water bath, and the reaction was quenched by adding 250 μL of 5N HCl. The quantity of trans-cinnamic acid resulting from enzymatic action on L-phenylalanine was quantified at a wavelength of 290 nm using a UV-VIS spectrophotometer (Model: MILTON ROY SPECTRONIC21 D, Denver, CO, USA). The concentration of cinnamic acid was deduced from a standard curve of trans-cinnamic acid, and PAL activity was expressed in micromoles of cinnamic acid produced per gram per minute on a fresh-weight basis.
Assay of PPO
PPO activity was assessed following a standard methodology [22]. Specifically, 1.5 mL of 0.1 M sodium phosphate buffer (pH 6.5) was introduced to 200 µL of the enzyme extract, and the mixture was mixed until homogeneity was achieved. To initiate the enzymatic reaction, 200 µL of 0.01 M catechol was added, and the activity was quantified by monitoring alterations in absorbance at 495 nm per minute per gram of fresh tissue weight.
Assay of ß-1,3 Glucanase
ß-1,3 glucanase activity was quantified through colorimetric analysis [23], with glucose release expressed as minutes per mg of the sample. Initially, a mixture of 62.5 µL of crude enzyme extract and 62.5 µL of 4% laminarin was incubated at 40 °C for 10 min. The reaction was halted by adding 375 µL of dinitrosalicylic acid (DNS) prepared by combining 300 mL of 4.5% NaOH with 880 mL containing 8.8 g of DNS and 22.5 g of potassium sodium tartrate. Subsequently, the solution was heated for 5 min in a boiling water bath. The resulting colored solutions were diluted with distilled water and vortexed. The spectrophotometric quantification of reducing sugars generated due to enzyme activity was performed at 500 nm using a UV-VIS spectrophotometer (Model: MILTON ROY SPECTRONIC21 D, Denver, CO, USA). Enzyme activity was expressed as µg glucose released per min per mg of the sample. The blank consisted of the crude extract preparation mixed with laminarin at 0 incubation time.
Assay of PO
PO activity was assessed by evaluating pyrogallol oxidation in the presence of hydrogen peroxide (H2O2) (Merck, Darmstadt, Germany), following the procedure outlined by Addy and Goodman (1972) with minor modifications [23]. Specifically, 0.01 mL of the enzyme extract was combined with 3.0 mL of 0.05 M pyrogallol and 0.5 mL of 3% H2O2 in a quartz cuvette, ensuring thorough mixing. Subsequently, the cuvette was inserted into a spectrophotometer set at 436 nm (Model: MILTON ROY SPECTRONIC21 D, Denver, CO, USA). A parallel cuvette containing the reaction mixture without leaf extract served as the blank. The alteration in optical density between 30 and 150 s at 436 nm was employed to generate the PO activity profile. A change in absorption of 0.01 per min was considered a unit of activity and expressed as units of activity per g of fresh tissue per min.
2.7. Gene-Expression Profile, Evaluated Through qRT-PCR Analysis
The expression profiles of defense genes (PR genes), viz., OsPR10a, OsPR1b, OsPR10a, and the bacterial blight-resistance genes Xa1 and Xa26 [24] were studied (Supplementary Table S2) to identify the best-performing treatments at 0, 48, and 96 h (h) post-inoculation. Ribonucleic acid (RNA) was extracted from the collected leaves using the Spectrum Plant Total RNA kit (Sigma, St. Louis, MO, USA) as per the manufacturer’s instructions with liquid nitrogen [25].
The extracted RNA and synthesized cDNA were quantified and assessed for purity with a Nanodrop 1000 (Thermo Scientific, Waltham, MA, USA). The quality of RNA and cDNA was assessed based on A260/A280 and A280/A260 ratios. Total RNA (10 µg) was used as a template to obtain a cDNA yield of 200 ng/µL with the help of the PrimeScript RT reagent Kit with gDNA Eraser (Takara, Osaka, Japan). Quantitative PCR was performed to obtain measurements of transcription of tested defense genes with gene-specific primers using the SYBR premix Ex Taq kit (Takara, Osaka, Japan). The temperature regime followed was as follows: 95 °C for 10 min; 40 cycles of 95 °C for 15 s, 55 °C for 30 s, 62 °C for 30 s; and 60 °C for 1 min.
Expression of each target OsPR gene was normalized to the expression of the constitutively expressed endogenous reference gene OsP1E6 in untreated, matched control tissues. The master mixture was prepared for 11 cDNA samples to avoid pipetting errors. The master mixture of 7 μL was added to each reaction with 3 μL cDNA, making the total reaction volume 10 μL, and each reaction mixture was added to a 96-well microtiter plate (Applied Biosystems, Waltham, MA, USA). The components were then mixed well by spinning in a mini centrifuge. Expression levels of each defense gene, as quantified from cDNAs, were analyzed in triplicate.
2.8. Statistical Analysis
All experimental data were subjected to rigorous statistical analyses, including analysis of variance (ANOVA) and post-hoc tests, using IBM SPSS Statistics 21 to discern significant differences among treatments.
3. Results
3.1. Confirmation of the Pathogen
Pathogenicity testing of X. oryzae pv. oryzae on susceptible rice plants (variety: Ranjit) revealed high virulence. Clip inoculation of rice with X. oryzae pv. oryzae resulted in typical symptoms of bacterial blight infection on the inoculated leaves, initially with water-soaked lesions and then with yellowing on the clipped parts of leaves within 10 days. The lesions had a wavy margin and progressed down towards the leaf margins. Eventually, the inoculated leaves dried up within 21 days (Figure 1). These observations align well with those of previous studies with successful X. oryzae pv. oryzae inoculation using the leaf-clipping method, confirming the association of the pathogen with the disease [9,11,12].

Figure 1.
Results of pathogenicity test showing (a) typical symptoms of bacterial blight, (b) symptom initiation on clipped leaf surface at 10 days after inoculation and (c) 25 days after inoculation (d) and pure culture of re-isolated X. oryzae pv. oryzae with typical yellow-colored colonies.
The bacterial blight pathogen, X. oryzae pv. oryzae, was re-isolated from symptomatic rice leaves, and the ooze test was conducted to verify the presence of the bacteria in the afflicted tissues. On nutrient agar plates, characteristic colonies of X. oryzae pv. oryzae were observed: light yellow, circular, convex, opaque, and smooth (Figure 1d). Morphologically, the bacterium exhibited a rod-shaped structure and maintained a red color upon counter-staining with safranin, indicative of its Gram-negative nature. Biochemically, positive reactions were observed in the KOH, citrate utilization, gelatin liquefaction, catalase, and levan production tests. These biochemical test results aligned with those earlier reported by Arshad et al. (2015) during their X. oryzae pv. oryzae identification study [26].
3.2. In Vitro Antagonistic Activity
The growth of both the bioagents, viz., T. asperellum and P. fluorescens, demonstrated compatibility with each other (Figure 2). In vitro assays unequivocally substantiated the potent antagonistic efficacy exhibited by T. asperellum and P. fluorescens against X. oryzae pv. oryzae. Distinct radial inhibition zones were formed due to the action of bioagents, signifying their pronounced suppressive impact on the pathogenic agent (Figure 3 and Figure 4 and Table 1); however, significant variations were recorded among the treatments in terms of the mean diameter of the inhibition zones at p < 0.05. The combination of bioagents, T. asperellum + P. fluorescens, showed higher efficacy (15.77 mm) against X. oryzae pv. oryzae compared to the individual bioagents P. fluorescens (12.74 mm) or Ta (11.42 mm).

Figure 2.
Compatibility test of T. asperellum and P. fluorescens: (a) pure culture of T. asperellum; (b) pure culture of P. fluorescens; (c) compatibility of T. asperellum + P. fluorescens (NA media); (d) compatibility of T. asperellum + P. fluorescens (PDA media), showing no zone of inhibition.

Figure 3.
In vitro antagonistic test of Trichoderma asperellum and Pseudomonas fluorescens against X. oryzae pv. oryzae. (a) Control (X. oryzae pv. oryzae alone); (b) inoculated disc of Trichoderma asperellum + X. oryzae pv. oryzae; (c) inoculated disc of Pseudomonas fluorescens + X. oryzae pv. oryzae; (d) inoculated disc of (Trichoderma asperellum and Pseudomonas fluorescens) + X. oryzae pv. oryzae. Clear zones indicating growth inhibition of X. oryzae pv. oryzae by Trichoderma asperellum and Pseudomonas fluorescens can be seen on X. oryzae pv. oryzae-seeded petri plates.

Figure 4.
In vitro antagonism of bioagents, expressed as percent inhibition of growth of X. oryzae pv. oryzae; T1: control (X. oryzae pv. oryzae alone), T2: T. asperellum + X. oryzae pv. oryzae, T3: P. fluorescens + X. oryzae pv. oryzae, T4: T. asperellum + P. fluorescens + X. oryzae pv. oryzae.

Table 1.
In vitro efficacy of Trichoderma asperellum and Pseudomonas fluorescens against X. oryzae pv. oryzae.
3.3. SEM Analysis
SEM analysis showed ultrastructural alterations in the cells of X. oryzae pv. oryzae, specifically, significant cell distortions and biofilm disruption, confirming the efficacy of T. asperellum and P. fluorescens in inhibiting X. oryzae pv. oryzae cells under in vitro conditions. The morphological damage suggested that these biocontrol agents interfere with essential cellular processes as part of their activity against bacterial blight disease in rice (Figure 5).

Figure 5.
SEM images showing the mode of action of T. asperellum and P. fluorescens: (a) control (X. oryzae pv. oryzae alone), (b) T. asperellum + P. fluorescens + X. oryzae pv. oryzae interaction showing suppression and distorted cells of X. oryzae pv. oryzae; (c) disruption of biofilm of X. oryzae pv. oryzae.
3.4. In Vivo Bio-Efficacy Response
3.4.1. Seed Germination and Plant Growth Parameters
The impact of bioagent treatments on seed germination and seedling vigor was observed to be highly significant. The combined treatment with T. asperellum + P. fluorescens was associated with a 12.63% higher germination rate compared to the untreated control. By contrast, T. asperellum and P. fluorescens alone yielded only 4.73% and 6.93% higher germination compared to the control, signifying the importance of the combined application of T. asperellum + P. fluorescens. The response to inoculation was also measured through seedling vigor indices (SVI), with a two-fold increase seen in T. asperellum + P. fluorescens-treated seedlings over control seedlings, highlighting the synergistic effects of the bioagents on early plant development. Bioagent treatments significantly enhanced the tillering of seedlings, with the combined application of T. asperellum + P. fluorescens yielding higher tillers than the control treatment. On the other hand, individual bioagents also influenced tillering, with P. fluorescens- and T. asperellum-treated plants yielding 1.2-fold and 1.3-fold higher tillering, respectively, compared to control plants. The effect of the application of the bioagents was also examined via measurements of plant height, and it was observed that 60 days after sowing, plants treated with the combined application of T. asperellum + P. fluorescens showed a maximum plant height of 65.5 cm, versus 56.7 cm in control plants. The combination of the fungal and bacterial bioagents yielded higher PGP parameters compared to treatment with the individual components. These observations suggest that there was much stronger PGP activity with the combined application of these two bioagents than with the individual bioagents (Table 2).

Table 2.
Analysis of PGP attributes and biocontrol potential of T. asperellum and P. fluorescens in pot experiments.
3.4.2. Response with Respect to Disease Index
The application of different treatments significantly reduced the Percent Disease Incidence (PDI) and Disease Severity (DS) in rice compared to those seen in control plants treated with X. oryzae pv. oryzae alone. A significant decrease in PDI of 76.21% was observed after the application of T. asperellum + P. fluorescens; the individual bioagents P. fluorescens and T. asperellum yielded only 57.40% and 56.40% reductions, respectively (Table 2). The combined application of T. asperellum + P. fluorescens yielded an 86.5% reduction in DS, with a minimum DS value of 9.5%; by comparison, there was only a 13.13% reduction in DS in plants treated with P. fluorescens and a 19.16% reduction in DS in plants treated with T. asperellum (Figure 6).

Figure 6.
Effects of different treatments on bacterial blight incidence (%) and severity (%) in pot-grown rice plants [T1 = positive control (Xoo); T2 = Ta; T3 = Pf; T4 = Ta + Pf; T5 = negative control (water)]. (Xoo = X. oryzae pv. oryzae; Ta = Trichoderma asperellum; Pf = Pseudomonas fluorescens).
3.5. Regulation of Defense Enzymes
All bioagent-treated plants showed a higher accumulation of defense enzymes compared to the control. PAL activity peaked at 48 h, with a 2.7-fold higher activity in T. asperellum + P. fluorescens-treated plants (Figure 7a), which slowed down gradually until 96 h. PO and PPO activities steadily increased, reaching maximal levels at 72 h irrespective of treatments in treated plants (Figure 7b), with the T. asperellum + P. fluorescens treatment resulting in a significant five-fold increase in PO activity (Figure 7c) compared to untreated plants. The highest total β-1,3-glucanase was found in plants treated with T. asperellum + P. fluorescens and was significantly greater than that in untreated X. oryzae pv. oryzae-infected or uninfected plants (Figure 7d).

Figure 7.
Induction of defense-related enzymes. (a) Phenylalanine ammonia-lyase (PAL), (b) polyphenol oxidase (PPO), (c) peroxidase, and (d) β-1,3-glucanase in rice plants inoculated with Pseudomonas fluorescens and Trichoderma asperellum and challenge inoculated with the causative pathogen of bacterial leaf blight. T1: positive control (Xoo); T2: Ta; T3: Pf; T4 = Ta + Pf; T5 = negative control (water); Xoo = X. oryzae pv. oryzae; Ta = Trichoderma asperellum; Pf = Pseudomonas fluorescens.
3.6. Expression of Defense Genes in Rice Due to the Application of T. asperellum + P. fluorescens
The qPCR data revealed upregulation of defense genes in response to T. asperellum + P. fluorescens application as compared with the untreated plants, and gene expression initiated at 0 h of treatment with T. asperellum + P. fluorescens + Xoo. The bacterial blight-resistance genes, viz., Xa1, were expressed from 0 h in the inoculated control, and Xa 26 was expressed at 48 h, while T. asperellum + Pf-treated plants challenged with inoculation of X. oryzae pv. oryzae showed expression at 0 h. Xa1 and Xa26 gene activity was significantly higher in bioagent-treated plants, peaking at 96 h with 14-fold higher activity of Xa1 and 7.3-fold increase of Xa26 activity in leaves inoculated with T. asperellum + P. fluorescens + Xoo than in leaves inoculated with X. oryzae pv. oryzae alone after 96 h. No expression of the Xa26 gene was observed in the uninoculated control at 0 and 48 h, and induction of gene expression was observed only at 96 h.
The expression of pathogenesis-related genes (PR), viz., OsPR1a, OsPR1b, and OsPR10a, was also triggered by bioagents and pathogens. OsPR1a and OsPR10a genes were expressed at 48 h after inoculation in X. oryzae pv. oryzae-treated control plants and uninoculated (DSW-treated) plants. In contrast, bioagent-treated plants expressed OsPR1a and OsPR10a from 0 h, and expression continued, reaching a peak at 96 h with 3.5-fold increased activity of OsPR1a and 5.9-fold greater activity of OsPR10a. The expression of OsPR1b was initiated at 48 h and was 4.0-fold higher in T. asperellum + P. fluorescens-treated plants. However, in uninoculated control plants (DSW treated), expression of this gene was observed only after 96 h of inoculation (Figure 8a–e).



Figure 8.
(a) The expression levels of Xa1 in Oryza sativa var. Ranjit populations under Xoo stress. The graph also represents the expression levels of the genes at 0, 48, and 96 h after application of the bioagent to plants that had undergone Xoo inoculation; the latter two values were significantly different compared with the expression levels at 0 h (p < 0.05) due to the application of the treatment. (b) The expression levels of Xa26 in Oryza sativa var. Ranjit populations under Xoo stress. The graph also represents the expression levels of the genes at 0, 48, and 96 h after application of the bioagent to plants that had undergone Xoo inoculation; the latter two values were significantly different compared with the expression levels at 0 h (p < 0.05) due to the application of the treatment. (c) The expression levels of OsPR1a in Oryza sativa var. Ranjit populations under Xoo stress. The graph also represents the expression levels of the genes at 0, 48, and 96 h after application of the bioagent to plants that had undergone Xoo inoculation; the latter two values were significantly different compared with the expression levels at 0 h (p < 0.05) due to the application of the treatment. (d) The expression levels of OsPR1b in Oryza sativa var. Ranjit populations under Xoo stress. The graph also represents the expression levels of the genes at 0, 48, and 96 h after application of the bioagent to plants that had undergone Xoo inoculation; the latter two values were significantly different compared with the expression levels at 0 h (p < 0.05) due to the application of the treatment. (e) The expression levels of OsPR10a in Oryza sativa var. Ranjit populations under Xoo stress. The graph also represents the expression levels of the genes at 0, 48, and 96 h after application of the bioagent to plants that had undergone Xoo inoculation; the latter two values were significantly different compared with the expression levels at 0 h (p < 0.05) due to the application of the treatment.
4. Discussion
X. oryzae pv. oryzae-related bacterial blight disease is a major threat to rice cultivation worldwide, and the systemic nature of the bacterial pathogen aggravates the pace of the disease, which results in a 20−30% annual reduction in rice production globally [3]. The present study highlights the potential of combining T. asperellum and P. fluorescens to manage bacterial blight disease. An analysis of in vitro assays and plant growth parameters demonstrated the multi-pronged role of these bioagents, which act both as growth promoters and as disease suppressors. Their effectiveness is attributed to direct antagonism against X. oryzae pv. oryzae pathogens and to the activation of plant defense mechanisms, offering a dual approach to disease management.
The inhibition of X. oryzae pv. oryzae by T. asperellum and P. fluorescens clearly highlights their efficacy as direct antagonists; P. fluorescens was more effective in this respect than T. asperellum. However, their combination was the most effective against the pathogen in vitro owing to their diverse modes of action. The inhibition of X. oryzae pv. oryzae by T. asperellum and P. fluorescens is the result of a combination of mechanisms involving the production of antimicrobial compounds such as lipopeptides, limonene, trichodermin, and siderophores like coprogen by Trichoderma spp. [27,28] and of phenazine, pyoluteorin, hexane dione, and 2,4-diacetylphloroglucinol by P. fluorescens [29]. These microorganisms also compete with the pathogen for essential nutrients and space, further inhibiting its growth [30].
SEM examination of X. oryzae pv. oryzae × T. asperellum × and P. fluorescens revealed discernible alterations in cell aggregation, reflecting disturbances in biofilm formation, and distorted X. oryzae pv. oryzae cells; together, these findings provide insights into the cellular-level interactions between the bioagents and the pathogen. X. oryzae pv. oryzae cells treated with the bioagents appeared shrunken, lysed, and distorted, as the bioagents caused rapid damage to the cell wall and membrane of the X. oryzae pv. oryzae cells, resulting in significant leakage of the intracellular substances and cytoplasmic fluid and in the death of the cells. This mechanism validates the potency of T. asperellum and P. fluorescens in inhibiting the pathogen. Pseudomonas species often form robust biofilms that occupy surfaces more quickly and extensively than X. oryzae pv. oryzae, and the bioagent can physically prevent Xanthomonas spp. from attaching and establishing its biofilm by colonizing surfaces early and forming dense biofilms [31]; this mechanism may contribute to the higher efficacy of P. fluorescens against X. oryzae pv. oryzae. The distortion in biofilm formation by X. oryzae pv. oryzae cells suggests that the bioagents T. asperellum and P. fluorescens interfere with this critical process, weakening the pathogen’s ability to establish infections. By preventing or disrupting biofilm formation, the bioagents expose the pathogen to greater environmental and host-derived pressures, making it more vulnerable [32,33]. A clear zone of inhibition signifies the metabolic response of bioagents against X. oryzae pv. oryzae, including production of enzymes (e.g., proteases, glucanases) by T. asperellum and P. fluorescens that degrade the cell walls of X. oryzae pv. oryzae. This degradation not only weakens the pathogen but may also inhibit its ability to reproduce or spread within the host plant. The cell-wall damage also leads to a loss of structural integrity, ultimately contributing to pathogen death or reduced virulence [34]. The superior performance of the T. asperellum + P. fluorescens combination may be attributed to the cumulative effect of diverse metabolites and modes of action of both antagonists [27,35].
Beyond the direct antagonism, the MBCAs benefit the plants through their functional polymorphism as growth promoters as well. The significant enhancement of seed germination and seedling growth observed with the co-application of T. asperellum and P. fluorescens can be attributed to the complementary mechanisms these bioagents provide beyond their antagonistic action. Both T. asperellum and P. fluorescens are known to produce various plant growth-promoting hormones, such as indole-3-acetic acid (IAA), gibberellins, and cytokinins. These hormones stimulate root elongation, improve seed germination, and enhance overall plant vigor [36,37]. The combined production of these substances by these bioagents results in a synergistic effect on early plant development [38]. Additionally, these microorganisms facilitate nutrient uptake by solubilizing phosphorus and other essential minerals in the soil, thereby improving the availability of nutrients to the plants. This nutrient enhancement is critical during the early stages of plant development, leading to increased seedling vigor and yield [39]. Another important factor is the ability of these bioagents to produce siderophores, which chelate iron and make it more accessible to plants, further contributing to improved growth [28]. The synergistic effect of Trichoderma and Pseudomonas likely amplifies these benefits, as they complement each other’s functions, leading to more vigorous plant development and thereby significantly increasing productivity [27,40].
In terms of disease management, both T. asperellum and P. fluorescens exhibit strong biocontrol activity against a wide range of plant pathogens through direct inhibitory effects and their ability to induce systemic resistance (ISR) in plants, priming the plant’s immune system to better fend off pathogens [41]. The enhanced activities of defense enzymes such as PAL, PO, and PPO in response to bioagent treatments suggest a significant enhancement of the plants’ resistance mechanisms. The significant elevation in PO activity indicates reinforcement of cell walls and detoxification of reactive oxygen species generated during pathogen attack [42]. PAL, as a key enzyme in the phenylpropanoid pathway, drives the synthesis of protective compounds like lignin and phytoalexins, strengthening the plant cell walls to hinder pathogen invasion and further spread. Additionally, an increase in PPO activity suggests that the bioagents are promoting the oxidation of phenolic compounds into quinones, which are toxic to pathogens, thus providing direct antimicrobial action. Together, these heightened enzymatic activities point to a strong, bioagent-induced defense system within the plant, which likely contributes towards reduced disease incidence and improved plant health [20,33]. Our study elucidates the host response in terms of the expression of important defense-related genes, viz., OsPR1a, OsPR1b, and OsPR10a and bacterial blight-resistant genes, viz., Xa1, and Xa26, due to the application of T. asperellum + P. fluorescens in rice challenged by X. oryzae pv. oryzae inoculation [43]. Inoculation with X. oryzae pv. oryzae alone could not induce up-regulation of these defense genes in rice plants. Expression of all the genes (Xa1, Xa26, OsPR1a, OsPR1b, and OsPR10a) was highly up-regulated at 96 h post-inoculation in samples treated with T. asperellum + P. fluorescens. OsPR1b was expressed only at 48 and 96 h post-inoculation, whereas all other genes were induced at 0 h of inoculation. Xa1 gene expression was induced on inoculation with a bacterial pathogen and wound; it is thus unlike other isolated resistance genes in plants, which show constitutive expression [25]. In the present investigation, it was observed that the increased expression of Xa1 and Xa26 genes was specifically triggered by the application of T. asperellum and P. fluorescens. The host defense response, involving the expression of pathogenesis-related (PR) genes (OsPR1a, OsPR1b, and OsPR10a), was activated upon exposure to X. oryzae pv. oryzae and significantly increased post-application of the bioagent. In X. oryzae pv. oryzae-inoculated plants, the genes Xa21, OsPR1a, OsPR1b, OsPR10a, and Xa26 are not upregulated during the juvenile stage but show increased expression in adult-stage leaves, typically 5−6 days post-infection [43]. This response is associated with the application of bioagents, which trigger a phenomenon known as induced systemic resistance (ISR) in mature plants. ISR primes the plants’ defense mechanisms, often including signaling molecules that contribute to both localized and systemic defense, thereby playing a crucial role in strengthening plant immunity against the pathogen X. oryzae pv. oryzae [37].
5. Conclusions
Our studies put forth a strong hypothesis in favor of controlling bacterial blight disease of rice through co-inoculation of T. asperellum and P. fluorescens by expanding the functional corridor of rhizosphere microbial networking. Besides their antagonism against X. oryzae pv. oryzae, T. asperellum and P. fluorescens jointly elicit a temporal activation of plant defense enzymes and upregulation of PR genes, thereby improving the agronomic response of rice through dual defense mechanisms. These insights into the mechanisms of action of bioinoculants against bacterial blight disease of rice need further field validation, and multiomic studies are required to examine the shift in the rhizosphere and endosphere micromes in rice in response to the application of bioinoculants.
Supplementary Materials
The following supporting information can be downloaded at: https://www.mdpi.com/article/10.3390/microbiolres16070151/s1, Figure S1: Phylogenetic tree showing the genetic relationship of the BB isolate to other isolates by using maximum likelihood method; Table S1: BB disease severity scores of rice based on the IRRI standard evaluation system; Table S2: Primer sequence details of defense and resistance genes [24].
Author Contributions
Conceptualization, P.B. (Popy Bora); Methodology, P.B. (Popy Bora); Software, A.S. and R.B.; Formal analysis, A.S., S.S.A. (Shenaz Sultana Ahmed), M.J.K. and S.S.A. (Shabrin Sultana Ahmed); Investigation, P.B. (Popy Bora), A.S., S.S.A. (Shenaz Sultana Ahmed), A.B. (Ashok Bhattacharyya) and A.R.; Resources, S.K.C., R.B., M.S., P.B. (Parinda Barua) and N.R.; Data curation, P.B. (Popy Bora), A.S., S.S.A. (Shenaz Sultana Ahmed), P.B. (Parinda Barua), M.J.K. and S.S.A. (Shabrin Sultana Ahmed); Writing—original draft, P.B. (Popy Bora), A.S., S.S.A. (Shenaz Sultana Ahmed), P.S. and B.S.; Writing—review & editing, P.B. (Popy Bora), S.K.C., A.S., S.S.A. (Shenaz Sultana Ahmed), P.S., A.B. (Ashok Bhattacharyya), A.R., M.R., B.S., P.K., M.B., R.S. and A.B. (Arunima Bharali); Visualization, P.B. (Popy Bora), R.B. and M.S.; Supervision, P.B. (Popy Bora), S.K.C., T.T., N.R., P.K. and M.B.; Funding acquisition, P.K., M.B., R.S. and A.B. (Arunima Bharali). All authors have read and agreed to the published version of the manuscript.
Funding
The research was supported by the Assam Agribusiness and Rural Transformation Project (APART) funded by IRRI (New Delhi), Directorate of Research (Agri), AAU, Jorhat, Assam.
Institutional Review Board Statement
Not applicable.
Informed Consent Statement
Not applicable.
Data Availability Statement
The original contributions presented in this study are included in the article/Supplementary Materials. Further inquiries can be directed to the corresponding author.
Acknowledgments
The authors acknowledge the Directorate of Research (Agri), Assam Agricultural University, Jorhat for all the facilities and technical guidance for conducting the study.
Conflicts of Interest
The authors declare no conflicts of interest.
References
- Nino-Liu, D.O.; Ronald, P.C.; Bogdanove, A.J. Xanthomonas oryzae pathovars: Model pathogens of a model crop. Mol. Plant Pathol. 2006, 7, 303–324. [Google Scholar] [CrossRef]
- Sanya, D.R.A.; Syed-Ab-Rahman, S.F.; Jia, A.; Onesime, D.; Kim, K.M.; Ahohuendo, B.C.; Rohr, J.R. A review of approaches to control bacterial leaf blight in rice. World J. Microbiol. Biotechnol. 2022, 38, 113. [Google Scholar] [CrossRef]
- Qudsia, H.; Akhter, M.; Riaz, A.; Haider, Z.; Mahmood, A. Comparative efficacy of different chemical treatments for paddy blast, brown leaf spot, and bacterial leaf blight diseases in rice (Oryza sativa L.). Appl. Microbiol. 2017, 3, 1000138. [Google Scholar] [CrossRef]
- Ansari, T.H.; Ahmed, M.; Ara, A.; Khan, M.A.I.; Mian, M.S.; Zahan, Q.S.A.; Tomita, M. Yield loss assessment of rice due to bacterial blight at different resistance levels. Bangladesh J. Plant Pathol. 2018, 34, 71–76. [Google Scholar]
- Sharma, P.; Bora, L.C.; Bora, P. In vitro evaluation on population dynamics of Pseudomonas fluorescens in suppression of bacterial blight of rice (Xanthomonas oryzae pv. oryzae) enriched with micronutrients. J. Soils Crops 2021, 31, 219–224. [Google Scholar]
- Tao, H.; Li, X.; Huo, H.; Cai, Y.; Cai, A. Bacillus velezensis Y6, a Potential and Efficient Biocontrol Agent in Control of Rice Sheath Blight Caused by Rhizoctonia solani. Microorganisms 2024, 12, 1694. [Google Scholar] [CrossRef]
- Moran-Diez, M.E.; Rubio, M.B.; Hermosa, R.; Monte, E. Trichoderma and the Plant Heritable Priming Responses. J. Fungi 2021, 7, 318. [Google Scholar] [CrossRef]
- Woo, S.L.; Hermosa, R.; Lorito, M.; Monte, E. Trichoderma: A multipurpose, plant-beneficial microorganism for eco-sustainable agriculture. Nat. Rev. Microbiol. 2023, 21, 312–326. [Google Scholar] [CrossRef]
- Chetia, S.K.; Kalita Monalisha Ali, M.S.; Das, B.C.; Ahmed, T. Variability of Xanthomonas oryzae pv. oryzae and introgression of BLB resistance in the popular rice varieties–Ranjit and Shraboni of Assam. Res. Crops 2016, 17, 336–341. [Google Scholar] [CrossRef]
- Ritbamrung, O.; Inthima, P.; Ratanasut, K.; Kawee, S.; Tepsuda, R.; Kittisak, B. Evaluating Xanthomonas oryzae pv. oryzae (Xoo) infection dynamics in rice for distribution routes and environmental reservoirs by molecular approaches. Sci. Rep. 2025, 15, 1408. [Google Scholar] [CrossRef]
- Li, Z.; Shen, S.; Xia, K. Integrative genomic and transcriptomic analysis of Xanthomonas oryzae pv. oryzae pathotype IV, V, and IX in China reveals rice defense-responsive genes. Phytopathol. Res. 2024, 6, 28. [Google Scholar] [CrossRef]
- Bora, P.; Gogoi, S.; Deshpande, M.V.; Garg, P.; Bhuyan, R.P.; Altaf, N.; Saha, N.; Borah, S.M.; Phukon, M.; Tanti, N. Rhizospheric Bacillus spp. exhibit miticidal efficacy against Oligonychus coffeae (Acari: Tetranychidae) of Tea. Microorganisms 2023, 11, 2691. [Google Scholar] [CrossRef] [PubMed]
- Dugassa, A.; Alemu, T.; Woldehawariat, Y. In-vitro compatibility assay of indigenous Trichoderma and Pseudomonas species and their antagonistic activities against black root rot disease (Fusarium solani) of faba bean (Vicia faba L.). BMC Microbiol. 2021, 21, 115. [Google Scholar] [CrossRef]
- Chowdappa, A.; Kamalakannan, A.; Kousalya, S.; Gopalakrishnan, C.; Venkatesan, K.; Raju, G.S. In vitro evaluation of antagonists against Xanthomonas axonopodis pv. punicae. Int. J. Pure App. Biosci. 2018, 6, 272–280. [Google Scholar] [CrossRef]
- Gashaw, T.; Sitotaw, B.; Yilma, S. Evaluation of Rhizosphere Bacterial Antagonists against Ralstonia solanacearum Causing Tomato (Lycopersicon esculentum) Wilt in Central Ethiopia. Int. J. Agron. 2022, 22, 6341555. [Google Scholar] [CrossRef]
- Das, S.; Kundu, S.; Meena, K.; Jha, R.K.; Varma, A.; Bahuguna, R.N.; Tripathi, S. Seed biopriming with potential bioagents influences physiological processes and plant defense enzymes to ameliorate sheath blight-induced yield loss in rice (Oryza sativa L.). World J. Microbiol. Biotechnol. 2023, 39, 136. [Google Scholar] [CrossRef]
- Mckinney, H.H. Influence of soil temperature and moisture on infection of wheat seedlings by Helminthosporium sativum. J. Agric. Res. 1923, 26, 195–217. [Google Scholar]
- Wheeler, B.E.J. An Introduction to Plant Disease; John Wiley and Sons Ltd.: London, UK, 1969; p. 301. [Google Scholar]
- Islam, M.R.; Chowdhury, R.; Roy, A.S.; Islam, M.N.; Mita, M.M.; Bashar, S.; Latif, M.A. Native Trichoderma induced the defense-related enzymes and genes in rice against Xanthomonas oryzae pv. oryzae (Xoo). Plants 2023, 12, 1864. [Google Scholar] [CrossRef]
- Bradford, M.M. A rapid and sensitive method for the quantitation of microgram quantities of protein utilizing the principle of protein-dye binding. Anal. Biochem. 1976, 72, 248–254. [Google Scholar] [CrossRef] [PubMed]
- Mayer, A.M.; Harel, E.; Ben-Shaul, R. Assay of catechol oxidase—A critical comparison of methods. Phytochemistry 1966, 5, 783–789. [Google Scholar] [CrossRef]
- Pan, S.Q.; Ye, X.S.; Kuc, J. Association of β-1,3-glucanase activity and isoform pattern with systemic resistance to blue mould in tobacco induced by stem injection with Peronospora tabacina or leaf inoculation with tobacco mosaic virus. Physiol. Mol. Plant Pathol. 1991, 39, 25–39. [Google Scholar] [CrossRef]
- Addy, S.K.; Goodman, R.N. Polyphenol oxidase and peroxidase activity in apple leaves inoculated with a virulent or an avirulent strain of Erwinia amylovora. Indian Phytopathol. 1973, 25, 575–579. [Google Scholar]
- Ponciano, G.; Yoshikawa, M.; Lee, J.L.; Ronald, P.C.; Whalen, M.C. Pathogenesis-related gene expression in rice is correlated with developmentally controlled Xa21-mediated resistance against Xanthomonas oryzae pv. oryzae. Physiol. Mol. Plant Pathol. 2006, 69, 131–139. [Google Scholar] [CrossRef]
- Gangwar, G.P.; Sinha, A.P. Comparative antagonistic potential of Trichoderma spp. against Xanthomonas oryzae pv. oryzae. Ann. Plant Prot. Sci. 2010, 18, 458–463. [Google Scholar]
- Arshad, H.M.; Naureen, S.; Saleem, K.; Ali, S.; Jabeen, T.; Babar, M.M. Morphological and biochemical characterization of Xanthomonas oryzae pv. oryzae isolates collected from Punjab in 2013. Adv. Life Sci. 2015, 2, 125–130. [Google Scholar]
- Bora, P.; Bora, L.C.; Bhuyan, R.P.; Hashem, A.; Abd-Allah, E.F. Bioagent consortia assisted suppression in grey blight disease with enhanced leaf nutrients and biochemical properties of tea (Camellia sinensis). Biol. Control 2022, 170, 104907. [Google Scholar] [CrossRef]
- Yang, R.; Li, S.; Li, Y.; Yan, Y.; Fang, Y.; Zou, L.; Chen, G. Bactericidal effect of Pseudomonas oryziphila sp. nov., a novel Pseudomonas species against Xanthomonas oryzae reduces disease severity of bacterial leaf streak of rice. Front. Microbiol. 2021, 12, 759536. [Google Scholar] [CrossRef]
- Howell, C.R. Mechanisms employed by Trichoderma species in the biological control of plant diseases: The history and evolution of current concepts. Plant Dis. 2003, 87, 4–10. [Google Scholar] [CrossRef]
- Vinale, F.; Sivasithamparam, K.; Ghisalberti, E.L.; Marra, R.; Woo, S.L.; Lorito, M. Trichoderma–plant-pathogen interactions. Soil Bio. Biochem. 2008, 40, 1–10. [Google Scholar] [CrossRef]
- Shoresh, M.; Harman, G.E.; Mastouri, F. Induced systemic resistance and plant responses to fungal biocontrol agents. Ann. Rev. Phytopathol. 2010, 48, 21–43. [Google Scholar] [CrossRef]
- Beneduzi, A.; Ambrosini, A.; Passaglia, L.M. Plant growth-promoting rhizobacteria (PGPR): Their potential as antagonists and biocontrol agents. Genet. Mol. Biol. 2012, 35, 1044–1051. [Google Scholar] [CrossRef]
- Bashan, Y.; de-Bashan, L.E.; Prabhu, S.R.; Hernandez, J.P. Advances in plant growth-promoting bacterial inoculant technology: Formulations and practical perspectives (1998–2013). Plant Soil 2014, 378, 1–33. [Google Scholar] [CrossRef]
- Contreras-Cornejo, H.A.; Macias-Rodriguez, L.; del-Val, E.; Larsen, J. Interactions of Trichoderma with plants, insects, and plant pathogen microorganisms: Chemical and molecular bases. In Co-Evolution of Secondary Metabolites; Springer: Cham, Switzerland, 2020; pp. 263–290. [Google Scholar]
- Compant, S.; Duffy, B.; Nowak, J.; Clement, C.; Barka, E.A. Use of plant growth-promoting bacteria for biocontrol of plant diseases: Principles, mechanisms of action, and future prospects. Appl. Environ. Microbiol. 2005, 71, 4951–4959. [Google Scholar] [CrossRef]
- Raaijmakers, J.M.; Paulitz, T.C.; Alabouvette, C.; Moënne-Loccoz, Y. The rhizosphere: A playground and battlefield for soil-borne pathogens and beneficial microorganisms. Rhizosphere Achiev. Chall. 2010, 104, 536. [Google Scholar]
- Bora, P.; Bora, L.C. Disease management in horticulture crops through microbial interventions: An overview. Indian J. Agric. Sci. 2020, 90, 1389–1396. [Google Scholar] [CrossRef]
- Bora, P.; Bora, L.C. Microbial antagonists and botanicals mediated disease management in tea, Camellia sinensis (L.) O. Kuntze: An overview. Crop Prot. 2021, 148, 105711. [Google Scholar] [CrossRef]
- Appu, M.; Ramalingam, P.; Sathiyanarayanan, A.; Huang, J. An overview of plant defense-related enzymes responses to biotic stresses. Plant Gene 2021, 27, 100302. [Google Scholar] [CrossRef]
- Ongena, M.; Jacques, P. Bacillus lipopeptides: Versatile weapons for plant disease biocontrol. Trends Microbiol. 2008, 16, 115–125. [Google Scholar] [CrossRef]
- Yoshimura, S.; Yamanouchi, U.; Katayose, Y.; Toki, S.; Wang, Z.X.; Kono, I.; Kurata, N.; Yano, M.; Iwata, N.; Sasaki, T. Expression of Xa1, a bacterial blight-resistance gene in rice, is induced by bacterial inoculation. Proc. Natl. Acad. Sci. USA 1998, 95, 1663–1668. [Google Scholar] [CrossRef]
- Rouina, H.; Tseng, Y.H.; Nataraja, K.N.; Uma Shaanker, R.; Oelmüller, R. Arabidopsis restricts sugar loss to a colonizing Trichoderma harzianum strain by downregulating SWEET11 and-12 and upregulation of SUC1 and SWEET2 in the roots. Microorganisms 2021, 9, 1246. [Google Scholar] [CrossRef]
- Sheikh, T.M.; Zhang, L.; Zubair, M.; Hanif, A.; Li, P.; Farzand, A.; Ali, H.; Bilal, M.S.; Hu, Y.; Chen, X.; et al. The type III accessory protein HrpE of Xanthomonas oryzae pv. oryzae surpasses the secretion role and enhances plant resistance and photosynthesis. Microorganisms 2019, 7, 572. [Google Scholar] [CrossRef] [PubMed]
Disclaimer/Publisher’s Note: The statements, opinions and data contained in all publications are solely those of the individual author(s) and contributor(s) and not of MDPI and/or the editor(s). MDPI and/or the editor(s) disclaim responsibility for any injury to people or property resulting from any ideas, methods, instructions or products referred to in the content. |
© 2025 by the authors. Licensee MDPI, Basel, Switzerland. This article is an open access article distributed under the terms and conditions of the Creative Commons Attribution (CC BY) license (https://creativecommons.org/licenses/by/4.0/).